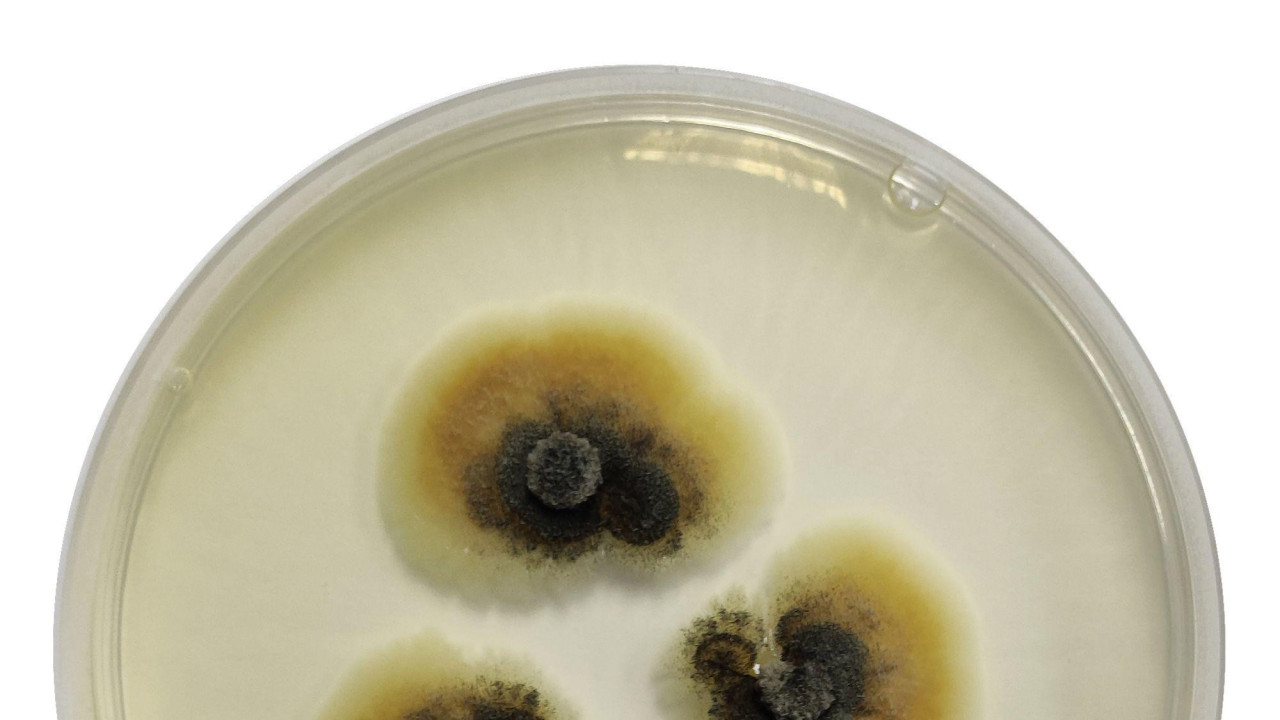
Mikroskopski prikaz nove vrste gljiva

BBC News
'Betmenova gamsia': Nova vrsta gljive nazvana po superheroju

betmenova gamsia, mikroskopski prikaz mikroorganizama - gljiva
Na koži slepog miša na istoku Srbije uočena je do sada nepoznata vrsta gljive. Naučnici su je simbolično nazvali po jednom od najpoznatijih superheroja - Betmenu.

Daleko od sunčeve svetlosti, među hodnicima Sesalačke pećine, na istoku Srbije, uočena je vrsta mikroorganizma do sada nepoznata u svetu nauke.
Pronađena je u brisu slepog miša, inače redovnog stanovnika ove pećine, i posle višemesečnih analiza utvrđeno je da je reč o novoj vrsti gljive.
Pošto je otkrivena na šišmišu naučnicu su je simbolično nazvali Gamsia batmanii, po mračnom vitezu sa crnim plaštom i maskom slepog miša - Betmenu.
Reč je o mikroorganizmu koji nije opasan za čoveka, jer ne može da raste na 37 stepeni, ali bi potencijalno mogao da bude za slepog miša, za šta su potrebna dodatna ispitivanja, kaže Željko Savković, sa odseka za alkologiju i mikologiju na Biološkom fakultetu.
„Sve gljive u pećinskim i drugim okruženjima su važne, jer se hrane raznim raspadnutim ostacima biljaka i životinja i tako doprinose kruženju materije i proticanju energije u ekosistemu.
„Mogu se naći u vazduhu, zemljištu ili sedimenata, ali je ovo prvi put da je baš izolovana iz pećine", objašnjava biolog za BBC na srpskom.
Od uočavanja do potvrde da je reč o novoj vrsti prošlo je dve godine, kada je 3. januara 2026. zvanično objavljen rad kojim je postala naučno potvrđena vrsta.
Ali otkud ova gljiva na istoku Srbije i zašto su važni slepi miševi?
Sesalačka pećina, na dva kilometra od Sesalca, sela po kojem je nazvana, smeštena je između planina Rtanj i Slemen na istoku Srbije.
Jedno je od važnijih staništa slepih miševa, gde naučnici beogradskog Biološkog fakulteta više od deset godina rade istraživanja zajedno sa članovima lokalnog Sokobanjskog ekološkog društva (SED).
Tokom terenskog rada do sada su otkrili značajne kolonije različitih vrsta slepih miševa, a među njima i evropskog dugokrilaša (Miniopterus schreibersii).
Na njegovoj koži je, pokazaće kasnije analize, bila upravo ova vrsta gljive.
Još se ne zna da li ju je slučajno mali sisar samo pokupio ili ona možda živi kao mikroorganizam na njegovoj koži i pomaže mu, objašnjava biolog Savković.

Slepi miševi su veoma važni članovi svakog ekosistema u kojem žive, ukazuje Jelena Burazerović, biloškinja.
„Oni nam prirodno nude besplatnu uslugu i kontrolišu brojnost insekata koji su štetni po poljoprivredne kulture i prenosioci su potencijalnih zaraznih bolesti.
„Praktično nam obezbeđuju zdravu hranu", objašnjava za BBC na srpskom.
Zato je važno, nadovezuje se njen kolega Savković, da se zaštite pećinska staništa, ali i slepi miševi, koji u Srbiji i imaju taj status.
„Ako želimo da imamo čistu vodu i vazduh, onda moramo da očuvamo i biodiverzitete", dodaje.
- Đokovićev duvalijus: Ova vrsta insekta dobila ime po srpskom sportisti
- Otkrivena nova vrsta insekta u Srbiji, nazvana po Ivani Španović
- Redak primerak: Albino slepo kuče pronađeno u Srbiji
Srbija je bogata kraškim predelima u kojima su pećine, a one su prirodni filteri za vodu i gde god da je krečnjačka podloga primetna je kvalitetnija voda, napominje biološkinja.
U ovoj pećini otkrivene su još dve nove vrste organizama za nauku - beskičmenjaci.
„Pomislili bismo da se nove vrste otkrivaju u prašumama, a zapravo eto ih u komšiluku", kaže Burazerović, koja godinama istražuje slepe miševe.
Oni su za naučnike poput zagonetke, jer imaju jak imuni sistem i spadaju među najdugovečnije organizme u odnosu na veličinu tela, dodaje.
„Neke vrste slepih miševa mogu da žive i do 42 godine, aktivni su uglavnom leti, a sisari su, poput nas.
„Želeli smo da saznamo koju mikrofloru imaju na sebi kao vid zaštite od raznih bolesti, a pomaže njihovom zdravlju", objašnjava.
Od Đokovića i Španović do Džegera i Trampa
Naučnici često u poznatim ličnostima, stvarnim ili izmišljenim, pronalaze inspiraciju za ime tek pronađene organizme.
Sitni svetlo narandžasti insekti bez očiju sa razvijenim čulom mirisa otkriveni u zapadnoj Srbiji nazvani su po jednom od najboljih tenisera svih vremena Novaku Đokoviću - duvaliu djokovici.
Tvrdokrilci zlatne boje bez očiju i i izduženih nogu i antena, Remyella spanovicae, dobili su ime po Ivani Španović, nekadašnjoj skakačici u dalj, sada troskokašici, najtrofejnijoj i jednoj od najboljih atletičarki u istoriji Srbije.
Po Miku Džegeru, pevaču britanske grupe Rolingstons, nazvan je puž - Anomphalus jaggerius, dok je gitarista legedarnom benda Kit Ričards bio inspiracija za naziv morskog stvorenja izumrlog pre 250 miliona godina, Perirehaedulus richardsi.
Pored političke doktrine, Donroova (verzija Monroove), po američkog predsedniku Donaldu Trampu se zove i vrsta vodozemca, otkrivena 2018.
Rekorder u ovoj kategoriji je nekadašnji američki predsednik Barak Obama po kojem je 14 različitih vrsta dobilo ime, a među njima pauk iz Kalifornije i mala koralna riba iz Obamine rodne države Havaji.
Pogledajte video: Slepa mišica Savka razbija tri najčešće zablude o njenoj vrsti
BBC na srpskom je od sada i na Jutjubu, pratite nas OVDE.
Pratite nas na Fejsbuku, Tviteru, Instagramu, Jutjubu i Vajberu. Ako imate predlog teme za nas, javite se na [email protected]
- Zašto slepi miševi nisu krivi za pandemiju korona virusa
- Ser Dejvid Atenboro, 'kum' tajanstvenih životinja i strašnih biljaka
- 'Tajni Amazon' engleske istraživačice Lusi Šepard: 'Džungla te proguta i ispljune'
- „Najmoćniji lešinar" posle pola veka iznad Srbije
- Slepa mišica Savka razbija zablude o njenoj vrsti
- Zašto budućnost tekile zavisi od meksičkih slepih miševa
- Trovanje pečurkama: Na šta treba da pazite kada berete gljive, a šta se dešava ako se otrujete
- Retka pojava u afričkom nacionalnom parku: Gorila rodila blizance




